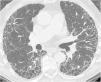

La patología de las vías respiratorias de medio calibre (bronquios segmentarios y subsegmentarios) es común y se presenta con síntomas respiratorios poco específicos, como tos, infecciones de repetición y en ocasiones hemoptisis. La dilatación permanente del árbol bronquial se conoce como «bronquiectasia» y representa un reto diagnóstico. El análisis de la distribución regional de las bronquiectasias en los diferentes lóbulos pulmonares es la guía diagnóstica más útil. El objetivo de este trabajo es describir los hallazgos de imagen de las bronquiectasias y sus diferentes tipos, revisar las situaciones más comunes y proponer un algoritmo diagnóstico basado en su distribución anatómica. Las bronquiectasias son un hallazgo frecuente, resultado de un amplio espectro de enfermedades. Los estudios de imagen desempeñan un papel esencial en su detección, clasificación y orientación diagnóstica hacia la patología subyacente
Diseases that involve the medium caliber airways (segmental and subsegmental bronchi) are common and present clinically with nonspecific respiratory symptoms such as cough, recurrent respiratory infections and occasionally, hemoptysis. The abnormal and irreversible dilation of bronchi is known as “bronchiectasis”. The diagnosis can be challenging and the analysis of the regional distribution of the bronchiectasis is the most useful diagnostic guide. The objective of this manuscript is to describe the main imaging findings of bronchiectasis and their classification, review the diseases that most commonly present with this abnormality, and provide an approach to the diagnosis based on their imaging appearance and anatomic distribution. Bronchiectasis is a frequent finding that may result from a broad range of disorders. Imaging plays a paramount role in diagnosis, both in the detection and classification, and in the diagnosis of the underlying pathology.